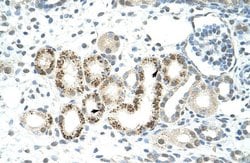
Invitrogen JMJD2D Polyclonal Antibody 100 &mu;L | Buy Online | Invitrogen&trade; | Fisher Scientific

missing translation for 'onlineSavingsMsg'
Learn More
Learn More
Invitrogen™ JMJD2D Polyclonal Antibody


Description
Peptide sequence: RAQELTLQTP AKRPLLAGTT CTASGPEPEP LPEDGALMDK PVPLSPGLQH Sequence homology: Human: 100%.
The JMJD2D gene encodes a member of the Jumonji C domain-containing histone demethylases, which are involved in the epigenetic regulation of gene expression by demethylating lysine residues on histone proteins. JMJD2D specifically interacts with β-catenin and is implicated in colorectal cancer, where it activates transcription of target genes and promotes cell proliferation, migration, and tumor formation. Structurally, JMJD2D belongs to the JMJD2 family but exhibits distinct features, lacking certain regions that make it the most structurally divergent within the family. Additionally, JMJD2D stabilizes and cooperates with the hepatitis B virus protein HBx, facilitating cccDNA transcription by demethylating H3K9me3 and counteracting the repressive effects of p53. JMJD2D's role in various cellular processes highlights its importance in both cancer pathogenesis and viral replication, making it a potential target in therapeutic research for colorectal cancer and hepatitis B.

Specifications
Specifications
| Antigen | JMJD2D |
| Applications | Immunohistochemistry, Western Blot |
| Classification | Polyclonal |
| Concentration | 0.5 mg/mL |
| Conjugate | Unconjugated |
| Formulation | PBS with 2% sucrose and 0.09% sodium azide |
| Gene | KDM4D |
| Gene Accession No. | Q6B0I6 |
| Gene Alias | FLJ10251; JHDM3D; JmjC domain-containing histone demethylation protein 3D; JMJD2D; jumonji domain containing 2D; jumonji domain-containing protein 2D; KDM4D; lysine (K)-specific demethylase 4D; lysine demethylase 4D; lysine-specific demethylase 4D |
| Gene Symbols | KDM4D |
| Show More |
Product Title
By clicking Submit, you acknowledge that you may be contacted by Fisher Scientific in regards to the feedback you have provided in this form. We will not share your information for any other purposes. All contact information provided shall also be maintained in accordance with our Privacy Policy.
Spot an opportunity for improvement?